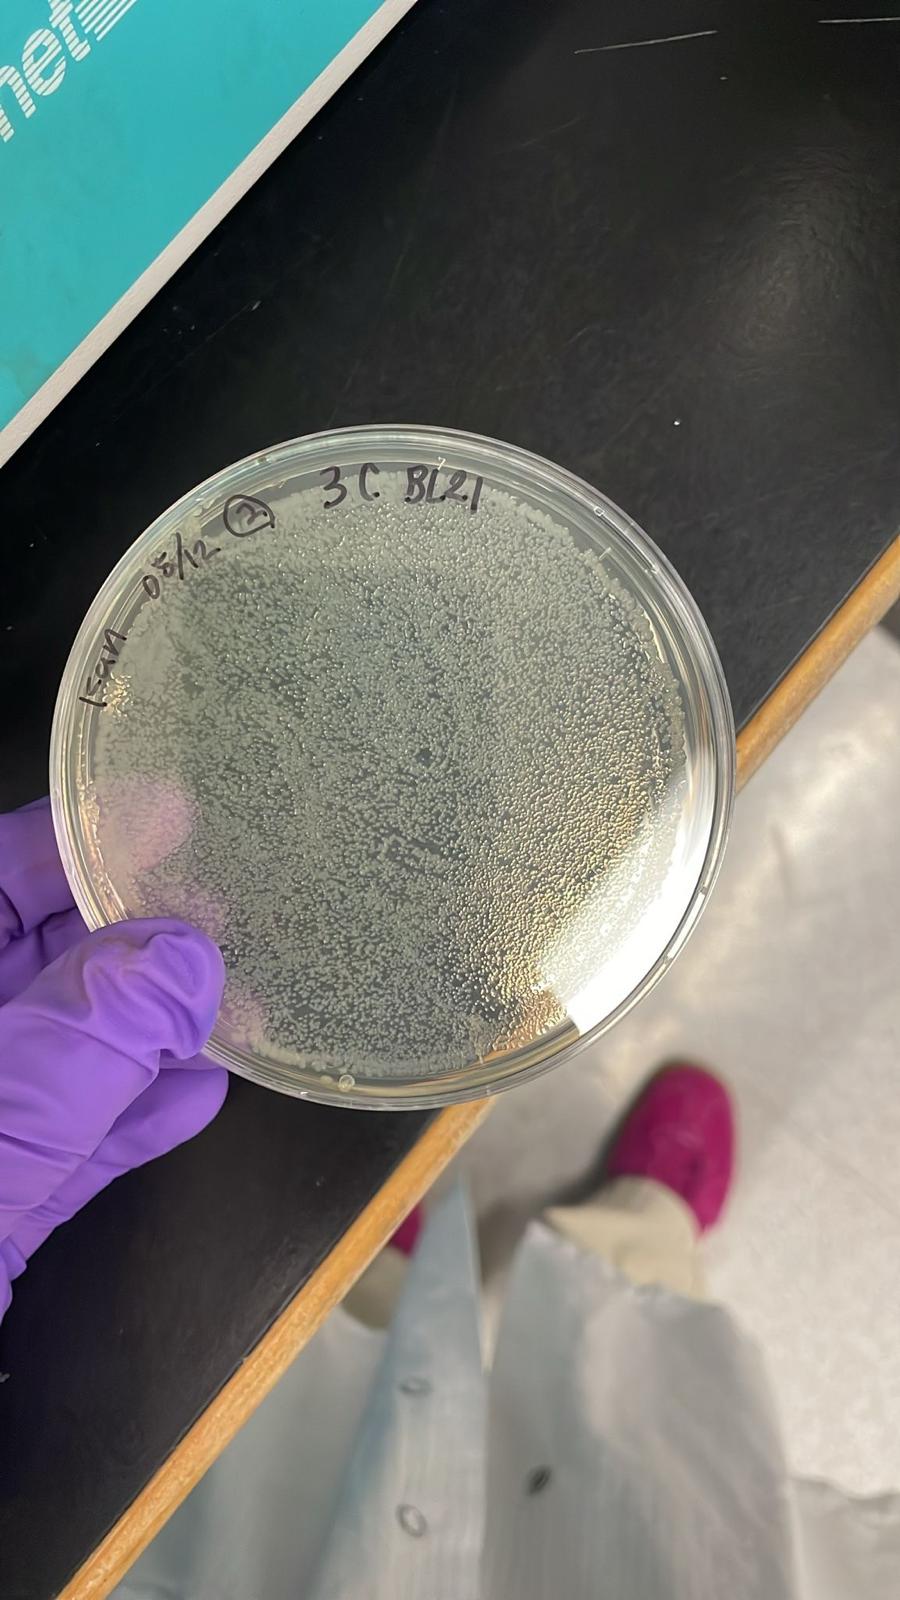

Exploring the boundaries of viral research


























Lab News
January 1st 2026– Lab is open at UBC
July 1, 2023- Dr. Mohamud receives inaugral CIHR Research Excellence, Diversity, and Independence Early Career Transition Award .
Exploring the boundaries of viral research

January 1st 2026– Lab is open at UBC
July 1, 2023- Dr. Mohamud receives inaugral CIHR Research Excellence, Diversity, and Independence Early Career Transition Award .